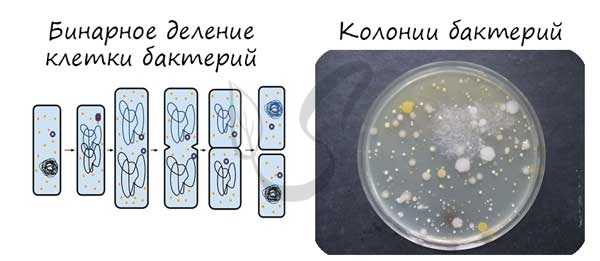
Колонии бактерий, бинарное деление бактерий

Обзор бактерий
Добавил пользователь Alex Обновлено: 28.01.2026
Данные бактерии могут быть классифицированы по их потребности в кислороде:
Факультативные анаэробы: аэробный или анаэробный рост при наличии или отсутствии кислорода
Микроаэрофильные анаэробы: требуется низкая концентрация кислорода (обычно 2–10%) и, для многих, высокая концентрация углекислого газа (например, 10%); в анаэробных условиях растут очень плохо
Облигатные анаэробы: не способны к аэробному метаболизму, но в различной степени толерантны к кислороду
Облигатные анаэробы размножаются на участках с низким окислительно-восстановительным потенциалом (например, на некротических, деваскуляризованных тканях). Кислород является токсичным для них. Облигатные анаэробы были классифицированы на основании их толерантности к кислороду:
Строгие анаэробы: выдерживают только ≤ 0,5% кислорода
Умеренные анаэробы: выдерживают от 2 до 8% кислорода
Аэротолерантные анаэробы: переносят атмосферный кислород в течение ограниченного времени
Облигатные анаэробы, которые обычно вызывают инфекцию, могут переносить атмосферный кислород в течение по меньшей мере 8 часов, а часто до 72 часов.
Облигатные анаэробы являются главными компонентами нормальной микрофлоры слизистых оболочек, особенно ротовой полости, нижнего отдела желудочно-кишечного тракта и влагалища; эти анаэробы вызывают заболевание в том случае, когда нарушены нормальные барьеры слизистой оболочки.
Грамотрицательные анаэробы и некоторые из инфекций, которые они вызывают, подразделяются на:
Bacteroides (наиболее распространенные): интраабдоминальные инфекции
Fusobacterium: абсцессы, раневые и респираторные инфекции, инфекционные заболевания ЦНС
Porphyromonas: аспирационная пневмония и периодонтит
Prevotella: внутрибрюшные инфекции и инфекции мягкой ткани
Грамположительные анаэробы и некоторые из инфекций, которые они вызывают, подразделяются на:
ActinomycesАктиномицеты: инфекции головы, шеи, брюшные, костные и тазовые инфекции, аспирационная пневмония ( актиномикоз Актиномикоз Актиномикоз – хроническая очаговая или гематогенная анаэробная инфекция, вызванная Actinomyces israelii и другими видами Actinomyces. Результатами инфекции являются локальный абсцесс. Прочитайте дополнительные сведенияКлостридии Краткий обзор клостридиальных инфекций (Overview of Clostridial Infections) Клостридии – спорообразующие, грамположительные, анаэробные бациллы, широко распространенные в пыли, почве и растительности, являются нормальной флорой в желудочно-кишечном тракте млекопитающих. Прочитайте дополнительные сведения : внутрибрюшные инфекции Клостридиальные интраабдоминальные и тазовые инфекции Clostridia, прежде всего Clostridium perfringens, распространены среди интрабдоминальных смешанных инфекций, вызванных разрывом внутреннего органа или воспалением тазовых органов. Симптомы. Прочитайте дополнительные сведения (например, клостридиальный некротизирующий энтерит Клостридиальный некротизирующий энтерит Клостридиальный некротизирующий энтерит — некроз тощей кишки и подвздошной кишки, вызванный Clostridium perfringens. Симптомы могут варьироваться от легкой диареи до септического шока. Прочитайте дополнительные сведения ), инфекции мягких тканей Клостридиальные инфекции мягкой ткани Клостридиальные инфекции мягкой ткани включают целлюлит, миозит и клостридиальный мионекроз. Эти нарушения обычно являются следствием травмы. Симптомы могут включать отек, боль, эмфизему с крепитацией. Прочитайте дополнительные сведения C. perfringens; пищевое отравление Clostridium perfringens Пищевое отравление Clostridium perfringens – острый гастроэнтерит, вызванный приемом в пищу загрязненной еды. Симптомы включают водянистую диарею и боли в животе. Диагностика проводится путем выявления. Прочитайте дополнительные сведения , вызываемое C. perfringens типа A; ботулизм Ботулизм Ботулизм – это отравление, вызванное токсином Clostridium botulinum, поражающее периферические нервы. Он может возникнуть и без инфекционного агента в случае, если имел место контакт. Прочитайте дополнительные сведения и младенческий ботулизм Младенческий ботулизм Младенческий ботулизм возникает в результате употребления внутрь продуктов питания, содержащих споры Clostridium botulinum, их колонизации в толстой кишке и выработки токсина in vivo. Прочитайте дополнительные сведения , вызываемые C. botulinum; столбняк Столбняк Столбняк – острое отравление нейротоксином, продуцируемым Clostridium tetani. Симптомами являются неустойчивые тонические судороги произвольно-сокращающихся мышц. Спазм поперечно-полосатой. Прочитайте дополнительные сведения C. tetani; а также диарея, вызванная Clostridioides (ранее Clostridium) difficile-индуцированный колит и диарея Clostridioide (ранее, Clostridium) difficile - индуцированная диарея Токсины, продуцируемые штаммами Clostridioides difficile в желудочно-кишечном тракте, вызывают псевдомембранозный колит, как правило, после использования антибиотиков. Симптомы включают. Прочитайте дополнительные сведения (псевдомембранозный колит)
Peptostreptococcus и Finegoldia: инфекции полости рта, дыхательных путей, костей и суставов, мягких тканей и интраабдоминальные инфекции
Cutibacterium (ранее Propionibacterium): инфекции, связанные с инородным телом (например, в шунте цереброспинальной жидкости, протезном суставе или кардиоустройстве)
Анаэробные инфекции, как правило, гноеродные и являются причиной формирования абсцессов и некроза тканей, а иногда септического тромбофлебита, газообразования, или того и другого. Многие анаэробы продуцируют разрушительные для тканей ферменты, так же как и некоторые из когда-либо известных мощнейших паралитических токсинов.
Признаками анаэробной инфекции являются:
Полимикробные результаты по грамокрашиванию или культуре бактерий
Бактерии обнаруживаются при окрашивании по Граму, но аэробные культуры стерильны
Газ в гное или зараженных тканях
Неприятный запах гноя или зараженных тканей
Некротические инфицированные ткани
Место инфекции около слизистой оболочки, для которой характерна анаэробная микрофлора
Обследование
Образцы для исследования на анаэробную культуру должны быть получены путем аспирации или биопсии обычно стерильных локусов. Доставка в лабораторию должна быть быстрой, а при транспортировке должна быть обеспечена бескислородная атмосфера с диоксидом углерода, водородом и азотом. Мазки лучше всего транспортируются в анаэробно стерилизованной, полутвердой среде, такой как транспортная среда Сary-Blair.
Авторское право © 2022 Merck & Co., Inc., Rahway, NJ, США и ее аффилированные лица. Все права сохранены.
Систематический обзор бактерий
Систематика. В систематике прокариот приняты следующие таксоны: отдел (тип), класс, порядок, семейство, род, вид. Современная классификация основана на объединении бактерий в группы по признаку сходства нуклеотидных последовательностей геномов.
Ниже приведены некоторые группы бактерий, представители которых имеют большое биологическое, медицинское и народнохозяйственное значение.
Актинобактерии. Примеры: бифидобактерии, актиномицеты, пропиопибактерии — элементы нормальной микробиоты человека; актиномицеты принимают участие в расщеплении сложных органических субстратов и почвообразовании, некоторые виды способны к азотфиксации и образованию клубеньков у небобовых растений; микобактерии — возбудители туберкулеза и лепры; пропионобактерии употребляют в сыроделии, а также для микробиологического синтеза витамина В12.
Бактероиды. Пример: бактероиды — элементы нормальной микробиоты кишечника человека.
Хламидии. Пример: хламидии — возбудители хронического воспалительного заболевания мочеполовых органов.
Фирмикуты. Примеры: лактобациллы и клостридии — элементы нормальной микробиоты кишечника человека, патогенные формы клостридий — возбудители столбняка, газовой гангрены, ботулизма; некоторые виды лактобацилл используются в производстве кисломолочных продуктов, кофе, какао и силоса, а также для ферментации овощей и мяса (в колбасном производстве); с помощью бактерий Clostridium acetobutylicum осуществляют ферментативное превращение крахмала в ацетон и бутиловый спирт; стафилококки и стрептококки — элементы нормальной микробиоты человека, патогенные формы кокков — возбудители пневмонии, гонореи, ревматизма, ангины, скарлатины, пищевых отравлений и др. заболеваний; свободно живущие формы играют важную роль в деструкции органических веществ и почвообразовательных процессах.
Протеобактерии. Примеры: кишечная палочка — элемент нормальной микробиоты кишечника человека; сальмонеллы — возбудители брюшного тифа, паратифа у человека и сальмонеллеза; ге- ликобактер — условно патогенный микроорганизм, обитающий в слизистой желудка и кишечника, в ряде случаев вызывает хронический гастрит.
Спирохеты. Примеры: Leptospira — возбудитель лептоспироза, Treponema pallidum — возбудитель сифилиса, Borellia recurrentis — возбудитель возвратного тифа.
Также важную роль играют Cyanobacteria (цианобактерии), рассмотренные отдельно далее.
Примечание. Наряду с упомянутой выше систематикой бактерий, основанной на анализе их генома, существует систематика, базирующаяся на наиболее характерных признаках прокариот, которые достаточно легко выявляются в лабораторных условиях (предложена американским микробиологом Дэвидом Берджи). Несмотря на то что данная систематика является искусственной, она в силу простоты и удобства использования нашла широкое применение при решении прикладных задач в медицине, ветеринарии, гигиене и других областях деятельности человека.
Морфофункциональная характеристика. Характерной особенностью морфологии бактерий является достаточно высокий уровень клеточной дифференцировки, что проявляется в значительном разнообразии форм их тела, а также выраженной способности вегетативных форм бактерий давать начало покоящимся структурам (назначение которых заключается в переживании неблагоприятных условий), существенно отличающимся по своей морфологии от исходных (споры, цисты).
Внутреннее строение в целом соответствует основным принципам структурной организации прокариот.
Рассмотрим далее особенности физиологии бактерии.
Существуют как неподвижные формы бактерий (примеры: стафилококки, бифидобактерии), так и подвижные формы (примеры: сальмонелла, бледная спирохета (возбудитель сифилиса)).
У бактерий встречаются два способа передвижения:
Передвижение путем скольжения распространено главным образом среди нитчатых форм бактерий: спирохет, некоторых микоплазм, миксобактерий, серобактерий. Строение локомоторного аппарата и механизм его функционирования заключаются в следующем. В периплазматичееком пространстве между клеточной стенкой п наружной мембраной располагаются аксиальные фибриллы (в количестве от 2 до 100), по химическому составу и строению сходные с бактериальными жгутиками. Один конец каждой фибриллы прикреплен около полюса клетки (напомним, что последняя имеет вытянутую форму), другой остается свободным. Бактерия содержит по два комплекта аксиальных фибрилл, фиксированных на противоположных полюсах. Каждая фибрилла по спирали обвивает клеточное тело. В центральной области бактерии их свободные концы перекрываются. Движение клетки осуществляется посредством вращения фибрилл в периплазматичееком пространстве, которое индуцирует возникновение эластической волны на поверхности клеточной оболочки. При этом бактерии могут совершать несколько видов движений: вращения вокруг продольной оси, изгибания, передвижение по винтовой или волнообразной траекториям (см. рис. 3.35 (т. 1, ч. 1)). Общим признаком всех прокариот, использующих данный механизм передвижения, является способность продуцировать слизь, которая, по всей вероятности, необходима для его полноценной реализации. Скорость поступательного движения бактерий с помощью механизма скольжения составляет приблизительно 2—11 мкм/с.
Показано, что миграции бактерий обусловлены неоднородностью среды и, как правило, носят целенаправленный характер (такие ориентированные в пространстве перемещения называются таксисами). Дело в том, что микроорганизмы снабжены специальными белками-рецепторами (вмонтированными в клеточную оболочку или располагающимися в цитоплазме), способными регистрировать не только внешние сигналы различной природы, но и их пространственные градиенты. В зависимости от характера раздражителя различают хемотаксис, термотаксис, вискозитаксис (движение в сторону среды с большей или меньшей вязкостью) и маг- нитотаксис (миграция по линиям магнитного поля Земли).
Питание может быть автотрофным и гетеротрофным.
К бактериям с автотрофным типом питания относятся фотосинтезирующие (особенности бактериального фотосинтеза заключаются в том, что в качестве источника Н + используется, как правило, сероводород, реже — соединения железа и азота; свободный кислород не образуется) и хемосинтезирующие бактерии (азотфиксирующие, нитрифицирующие, серобактерии, железобактерии и др.).
Примеры бактерий с гетеротрофным типом питания — сапрофиты и паразиты.
Бактерии могут быть аэробными и анаэробными.
К аэробным бактериям относят группу микроорганизмов, которым для осуществления процессов жизнедеятельности необходим кислород (т.е. они осуществляют дыхание). Пример: молочнокислые бактерии.
Анаэробные бактерии не нуждаются в поступлении кислорода. Они подразделяются на строгих анаэробов, которые могут жить только в бескислородной среде, например возбудители столбняка, газовой гангрены, ботулизма, некоторые почвенные бактерии, и нестрогих, способных существовать как в присутствии кислорода, так и без него (дифтерийная палочка, энтеробактерии).
Возможны бесполое размножение (поперечное деление) и половой процесс (конъюгация и обмен генетическими элементами, сходными с плазмидами) (рис. 7.10).
Примечание. Тот факт, что в результате бесполого размножения образуются две идентичные жизнеспособные особи, вовсе не означает бессмертность бактерий. Установлено, что определенная часть особей поги-
Рис. 7.10. Конъюгация у бактерий
Рис. 7.11. Формирование эндоспор у бактерий бает в результате программированной смерти (апоптоза), другие — вследствие инфицирования бактериофагами.
5. Способность к спорообразованию.
Как указывалось выше, в неблагоприятных условиях большинство бактерий образуют споры или цисты. Процесс сводится к обособлению части цитоплазмы с ДНК (последняя предварительно реплицируется) и формированию вокруг нее плотных и прочных оболочек. У некоторых бактерий споры образуются внутри клетки, а затем обособляются (такие споры называются эндоспорами) (рис. 7.11). Метаболизм споры находится в угнетенном состоянии, она не питается и не размножается.
Бактерии
Бактерии (греч. bakterion - палочка) - простые одноклеточные микроскопические организмы, принадлежащие к прокариотам. В пищевых цепях они играют важнейшую роль редуцентов: разлагают органические вещества мертвых животных и растений.

Бактерии обладают исключительной устойчивостью: их можно обнаружить даже на стенках ядерного реактора. Такая способность связана с их быстрым размножением - при благоприятных условиях бактерии делятся каждые 20 минут. При изменении условий внешней среды (за счет мутаций) выживают и размножаются те формы, которые устойчивы к действию того или иного фактора (к примеру, радиации).
Строение бактерий
Бактерии имеют клеточную стенку, состоящую из муреина (пептидогликана) и выполняющую защитную функцию. У бактерий (прокариот, доядерных) отсутствуют мембранные органоиды. В их клетке можно найти только немембранные: рибосомы, жгутики, пили. Пили - поверхностные структуры, которые служат для прикрепления бактерии к субстрату.
Наследственный материал находится прямо в цитоплазме (не в ядре, как у эукариот) в виде нуклеоида. Нуклеоид (лат. nucleus - ядро + греч. eidos вид) - одна сложная кольцевидная молекула ДНК, не ограниченная мембранами от остальной части клетки.

Долгое время выделяли "особый органоид" бактерий - мезосомы, считали, что они могут участвовать в некоторых клеточных процессах.
Спешу сообщить, что на данный момент установлено однозначно: мезосомы это складки цитоплазматический мембраны, образующиеся только лишь при подготовке бактерий к электронной микроскопии (это артефакты, в живой бактерии их нет).

При наступлении неблагоприятных для жизни условий бактерии образуют защитную оболочку - спору. При образовании споры клетка частично теряет воду, уменьшаясь при этом в объеме. В таком состоянии бактерии могут сохраняться тысячи лет!
В состоянии споры бактерии очень устойчивы к изменениям температуры, механическим и химическим факторам. При изменении условий среды на благоприятные, бактерии покидают спору и приступают к размножению.

Энергетический обмен бактерий
Бактерии получают энергию за счет окисления веществ. Существуют аэробные бактерии, живущие в воздушной среде, и анаэробные бактерии, которые могут жить только в условиях отсутствия кислорода.
К аэробным бактериям относят многочисленных редуцентов, которые разлагают органические вещества мертвых растений и животных. Анаэробные бактерии составляют микрофлору нашего кишечника - бескислородную среду обитания.

Получают энергию бактерии путем хемо- или фотосинтеза. Среди хемосинтезирующих бактерий можно встретить нитрифицирующие бактерии, железобактерии, серобактерии.
Важно заметить, что клубеньковые бактерии (азотфиксирующие) не осуществляют хемосинтез: клубеньковые бактерии относятся к гетеротрофам.
Среди фотосинтезирующих бактерий особое место принадлежит цианобактериями (сине-зеленым водорослям). Благодаря им сотни миллионов лет назад возник кислород, а с ним и озоновый слой: появилась жизнь на поверхность земли и аэробный тип дыхания (поглощение кислорода), которым мы сейчас с вами пользуемся :)
Что касается бактерий гетеротрофов, то их способ питания основан на разложении останков животных и растений - сапротрофы (редуценты), либо же они питаются органами и тканями животных и растений - паразиты.

Биотехнология
Бактерии широко применяются в направлении биотехнологии - генной инженерии. Их используют для получения различных химических веществ (белков).
В ДНК бактерии вставляют нужный ген (к примеру, ген, кодирующий белковый гормон - инсулин), бактерия принимает новый участок гена за свой собственный, в результате чего начинает синтезировать белок с данного участка. На рибосомах подобных бактерий синтезируется инсулин, который человек собирает, обрабатывает и использует как лекарство.

Бактерии используются для получения антибиотиков (тетрациклина, стрептомицина, грамицидина), широко применяемых в медицине. Бактерии также применяют в пищевой промышленности, где их используют для получения молочнокислых продуктов, алкогольных напитков.
Классификация бактерий по форме
При микроскопии становятся заметны явные отличия форм бактерий.
- Стафилококки - их скопления похожи на виноградные грозди
- Диплококки - округлой формы, расположенные попарно
- Стрептококки - объединяются в цепочки, напоминающие нити жемчуга
- Палочки
- Вибрионы - изогнутые в виде запятой
- Спириллы - спирально извитые палочки
- Спирохеты - сильно извитые (до 10-15 витков) палочки

Размножение бактерий
Бактерии, как прокариоты (доядерные организмы), не могут делиться митозом, так как основное условие митоза - наличие ядра. Бактерии делятся бинарным делением клетки.
В ходе бинарного деления бактерия делится на две дочерние клетки, являющиеся генетическими копиями материнской. Деление в среднем происходит раз в 20 минут, популяция бактерий растет в геометрической прогрессии.
При размножении в лабораторных условиях бактерии образуют колонии. Колонии - видимые невооруженным глазом скопления клеток, образуемые в процессе роста и размножения микроорганизмов на питательном субстрате. Колонии выращиваются в чашках Петри.
Бактериальные инфекции
Многие патогенные бактерии приводят к развитию тяжелых заболеваний у человека. На настоящий момент при бактериальных инфекциях применяются антибиотики, дающие хороший эффект.
От некоторых болезней: дифтерия, коклюш и т.д. разработаны вакцины, дающие стойкий пожизненный иммунитет. После вакцинации образуются антитела к возбудителю, вследствие чего организм становится защищен от подобных инфекций: при встрече с возбудителем человек не заболевает, или переносит болезнь в легкой форме.
К бактериальным инфекциям относятся: чума, дифтерия, туберкулез, коклюш, гонорея, сифилис, тиф, столбняк, брюшной тиф, сальмонеллез, дизентерия, холера. Ниже вы можете видеть возбудителей данных заболеваний и место их локализации в организме.

Для борьбы с бактериями, вирусами и грибами в медицинских учреждениях (уже часто и в домашних условиях) используется кварцевание. Кварцевание - процесс обеззараживания помещения, суть которого в лампе, испускающей ультрафиолетовое излучение, губительное для микроорганизмов.
При проведении медицинских процедур локального кварцевания (облучения УФ отдельных участков) тела следует надевать защитные очки для избежания ожога сетчатки глаза. При кварцевании помещений следует покинуть их по той же причине.

Данная статья написана Беллевичем Юрием Сергеевичем и является его интеллектуальной собственностью. Копирование, распространение (в том числе путем копирования на другие сайты и ресурсы в Интернете) или любое иное использование информации и объектов без предварительного согласия правообладателя преследуется по закону. Для получения материалов статьи и разрешения их использования, обратитесь, пожалуйста, к Беллевичу Юрию.
В этот самый момент, человек, когда ты читаешь эти строки, ты получаешь пользу от работы бактерий. От кислорода, который мы вдыхаем, до питательных веществ, которые извлекает желудок из еды, нам нужно благодарить бактерий за процветание на этой планете. В нашем организме микроорганизмов, включая бактерий, больше, чем наших собственных клеток примерно в десять раз. По сути, мы больше микробы, чем люди.

Только недавно мы начали понемногу понимать микроскопические организмы и их влияние на нашу планету и здоровье, но история показывает, что много веков назад наши предки уже использовали мощь бактерий, ферментируя продукты питания и напитки (кто-нибудь слышал о хлебе и пиве?).
В 17 веке мы начали изучать бактерий уже непосредственно в наших телах в тесной связи с нами — во рту. Любопытство Антони ван Левенгука позволило обнаружить бактерии, когда он изучал бляшку между его собственными зубами. Ван Левенгук поэтически описал бактерий, обозначив бактериальную колонию на своих зубах как «немного белого вещества, похожего на застывшее тесто». Разместив образец под микроскопом, ван Левенгук увидел, что микроорганизмы движутся. Так они живые!
Вы должны знать, что бактерии сыграли важнейшую роль для Земли, став ключевым моментом в создании пригодного для дыхания воздуха и биологического богатства планеты, которую мы зовем домом.
В этой статье мы предоставим вам общую картину об этих крошечных, но очень влиятельных микроорганизмах. Мы рассмотрим хорошие, плохие и совершенно причудливые способы, которыми бактерии формируют историю человека и окружающей среды. Для начала рассмотрим, чем бактерии отличаются от других видов жизни.
Основы бактерий

Ученые разработали мощные микроскопы, чтобы взглянуть на бактерий — их размеры варьируются от одного до нескольких микрон (миллионной части метра) — и выяснить, как они соотносятся с другими формами жизни, растениями, животными, вирусами и грибками.
Как вы, возможно, знаете, клетки — это строительные кирпичики жизни, из них состоят и ткани нашего тела, и дерево, которое растет за окном. Люди, животные и растения обладают клетками с генетической информацией, заключенной в мембране под названием ядро. Эти типы клеток, которые называются эукариотическими, обладают специальными органеллами, каждая из которых выполняет уникальную работу, помогая клетке работать.
Бактерии, однако, не имеют ядер, и их генетический материал (ДНК) свободно плавает внутри клетки. У этих микроскопических клеток нет органелл и они обладают другими методами воспроизводства и передачи генетического материала. Бактерии считаются прокариотическими клетками.
Основные категории бактерий ученые оценивают по следующим параметрам:
- Выживают ли бактерии в среде с кислородом или без
- Их форма: палочки (bacillus), круги (cocci) или спирали (spirillum)
- Являются ли бактерии грамотрицательными или грамположительными, то есть обладают ли внешней защитной мембраной, препятствующей окрашиванию внутренностей клетки
- Как бактерии перемещаются и изучают окружающую среду (у многих бактерий есть жгутики, крошечные плетевидные структуры, которые позволяют им передвигаться в среде)
Микробиология — наука о всех типах микробов, включая бактерии, археи, грибы, вирусы и простейшие — позволяет отличать бактерии от их микробных братьев.
Похожие на бактерии прокариоты, ныне классифицирующиеся как археи, когда-то были вместе с бактериями, но когда ученые узнали о них больше, они предоставили бактериям и археям собственные категории.
Микробное питание (и миазма)

Некоторые бактерии — автотрофы — используют основные ресурсы вроде солнечного света, воды и химических веществ из окружающей среды для создания пищи (подумайте о цианобактериях, которые превращали солнечный свет в кислород в течение 2,5 миллионов лет). Другие бактерии ученые называют гетеротрофами, потому что они черпают энергию из существующих органических веществ в качестве пищи (к примеру, мертвые листья на лесной почве).
Правда в том, что то, что может быть вкусным для бактерий, будет нам противно. Они развивались, чтобы поглощать все типы продуктов, от разливов нефти и побочных продуктов ядерного распада до человеческих отходов и продуктов разложения.
Но склонность бактерий к конкретному источнику питания может принести пользу обществу. К примеру, специалисты по искусствам из Италии обратились к бактериям, которые могут поедать избыточные слои соли и клея, снижающие долговечность бесценных художественных произведений. Умение бактерий перерабатывать органические вещества также очень полезно для Земли, как в почве, так и в воде.
Исходя из ежедневного опыта, вы хорошо знакомы с запахом, который вызывают бактерии, поглощающие содержимое вашей мусорной корзины, перерабатывая остатки пищи и испуская собственные газообразные побочные продукты. Однако этим все не ограничивается. Вы также можете обвинить бактерии в том, что они вызывают эти неловкие моменты, когда вы сами испускаете газы.
Одна большая семья

Бактерии растут и образуют колонии, когда выпадает шанс. Если еда и экологические условия являются благоприятными, они размножаются и образуют липкие скопления, так называемые биопленки, чтобы выжить на разных поверхностях — от горных пород до зубов вашего рта.
У биопленок есть свои плюсы и минусы. С одной стороны, они взаимовыгодны природным объектам (мутуализм). С другой же — они могут быть серьезной угрозой. К примеру, врачи, которые лечат пациентов с медицинскими имплантатами и устройствами, серьезно озабочены биопленками, поскольку они представляют собой этакую недвижимость для бактерий. После колонизации биопленки могут вырабатывать побочные продукты, которые токсичны — а иногда и смертельны — для человека.
Как и люди в городах, клетки в биопленке сообщаются друг с другом, обмениваются информацией о продуктах питания и потенциальной опасности. Но вместо того, чтобы звонить соседям по телефону, бактерии отправляют записки с помощью химических веществ.
Также бактерии не боятся жить самостоятельно. Некоторые виды разработали интересные способы, чтобы выживать в суровых условиях. Когда еды больше нет, а условия становятся невыносимыми, бактерии консервируют себя, создавая жесткую оболочку — эндоспору, которая помещает клетку в состояние покоя и сохраняет генетический материал бактерии.
Ученые находят бактерии в таких временных капсулах, которые хранились и 100, и даже 250 миллионов лет. Это говорит о том, что бактерии могут самостоятельно храниться в течение длительного времени.
Теперь, когда мы знаем, какие возможности предоставляют колонии бактериям, давайте разберемся, как они попадают туда — путем деления и размножения.
Размножение бактерий

Как бактерии создают колонии? Как и другим формам жизни на Земле, бактериям нужно самокопироваться, чтобы выживать. Другие организмы делают это путем полового размножения, но не бактерии. Но сначала давайте обсудим, почему разнообразие — это хорошо.
Жизнь проходит естественный отбор, ну или селективные силы определенной среды позволяют одному типу процветать и размножаться больше, чем другому. Возможно, вы помните, что гены — это механизм, который инструктирует клетку, что ей делать, и определяет, какого цвета будут ваши волосы и глаза. Вы получаете гены от своих родителей. Половое размножение приводит к мутациям, или случайным изменениям в ДНК, что создает разнообразие. Чем больше генетического разнообразия, тем больше шансов, что организм сможет приспособиться к ограничениям окружающей среды.
Для бактерий воспроизводство не зависит от встречи с правильным микробом; они просто копируют собственную ДНК и делятся на две идентичных клетки. Этот процесс, называемый двоичным делением, происходит, когда одна бактерия делится на две, копируя ДНК и передавая ее обеим частям разделенной клетки.
Поскольку в конечном итоге рожденная клетка будет идентична той, из которой была рождена, такой метод размножения не самый лучший для создания разнообразного генофонда. Как же бактерии приобретают новые гены?
Оказывается, бактерии используют хитрый трюк: горизонтальный перенос генов, или обмен генетическим материалом без воспроизводства. Есть несколько способов, которые используют бактерии для этого. Один способ включает сбор генетического материала из окружающей среды вне клетки — из других микробов и бактерий (через молекулы под названием плазмиды). Другой способ — вирусы, которые используют бактерии в качестве дома. Заражая новую бактерию, вирусы оставляют генетический материал предыдущей бактерии в новой.
Обмен генетическим материалом дает бактериям гибкость к адаптации, и они адаптируются, если чувствуют стрессовые изменения в окружающей среде, такие как нехватка продовольствия или химические изменения.
Понимание того, как адаптируются бактерии, чрезвычайно важно для борьбы с ними и создания антибиотиков в медицине. Бактерии могут обмениваться генетическим материалом так часто, что порой лечение, которое работало раньше, уже не работает.
Ни высоких гор, ни большой глубины

Бактерии обнаруживаются практически везде на Земле. Невозможно представить количество бактерий на планете одновременно, но по некоторым оценкам их число составляет (бактерий и архей вместе) 5 октиллионов — это число с 27 нулями.
Классификация видов бактерий чрезвычайно сложна по понятным причинам. Сейчас есть примерно 30 000 официально идентифицированных видов, но база знаний постоянно растет, и есть мнения, что перед нами только верхушка айсберга от всех видов бактерий.
Правда в том, что бактерии были вокруг на протяжении очень долгого времени. Они породили одни из самых древних окаменелостей, которым 3,5 миллиарда лет. Результаты научных исследований позволяют предположить, что цианобактерии начали создавать кислород примерно 2,3—2,5 миллиарда лет назад в мировом океане, насытив атмосферу Земли кислородом, которым мы дышим по сей день.
Бактерии могут выживать в воздухе, воде, почве, льде, на жаре, на растениях, в кишечнике, на коже — везде.
Некоторые бактерии являются экстремофилами, то есть могут противостоять экстремальным условиям, когда либо очень жарко или холодно, либо отсутствуют питательные вещества и химикаты, которые мы обычно ассоциируем с жизнью. Исследователи обнаружили такие бактерии в Марианской впадине, самой глубокой точке на Земле на дне Тихого океана, возле гидротермальных источников в воде и во льду. Встречаются также бактерии, которые любят высокую температуру — такие, например, окрашивают опалесцирующий бассейн в Йеллоустонском национальном парке.
Плохие (для нас)

Хотя бактерии делают важный вклад в здоровье человека и планеты, у них есть и темная сторона. Некоторые бактерии могут быть патогенными, то есть вызывать заболевания и болезни.
На протяжении истории человечества некоторые бактерии (понятно почему) получили плохую репутацию, вызвав панику и истерию. Взять, к примеру, чуму. Бактерия, вызывающая чуму — чумная палочка Yersinia pestis — не только убила более 100 миллионов человек, но и, возможно, внесла свой вклад в распад Римской империи. До появления антибиотиков, лекарств, которые способствуют борьбе с бактериальными инфекциями, их было очень сложно остановить.
Даже сегодня эти патогенные бактерии серьезно нас пугают. Благодаря выработке устойчивости к антибиотикам, бактерии, вызывающие сибирскую язву, пневмонию, менингит, холеру, сальмонеллез, ангину и прочие болезни, которые еще и остаются рядом с нами, всегда представляют опасность для нас.
Особенно верно это для золотистого стафилококка, бактерии, ответственной за стафилококковые инфекции. Эта «сверхбактерия» приводит к появлению многочисленных проблем в клиниках, поскольку пациенты весьма часто подхватывают эту инфекцию при внедрении медицинских имплантатов и катетеров.
Биологическое оружие — еще один пугающий аспект этой беседы. Бактерий можно использовать как оружие в некоторых случаях, в частности, сибирскую язву так и использовали в одно время. Кроме того, не только люди страдают от бактерий. Отдельный вид — Halomonas titanicae — проявил аппетит к затонувшему океанскому лайнеру «Титаник», разъедая металл исторического корабля.
Конечно, бактерии могут приносить не только вред.
Героические бактерии
Давайте изучим хорошую сторону бактерий. В конце концов, эти микробы подарили нам такие вкусные продукты, как сыр, пиво, закваску и другие ферментированные элементы. Они также улучшают здоровье людей и используются в медицине.
Отдельных бактерий можно поблагодарить за формирование человеческой эволюции. Наука собирает все больше данных о микрофлоре — микроорганизмах, которые живут в наших телах, особенно в пищеварительной системе и кишечнике. Исследования показывают, что бактерии, новые генетические материалы и разнообразие, которое они приносят в наши тела, позволяют людям адаптироваться к новым источникам пищи, которые раньше не использовались.
Посмотрим на это с другой стороны: выстилая поверхность вашего желудка и кишечника, бактерии «работают» на вас. Когда вы едите, бактерии и другие микробы помогают вам разбивать и добывать питательные вещества из пищи, особенно углеводы. Чем разнообразнее бактерии, которых мы потребляем, тем больше разнообразия получают наши тела.
Хотя наши знания о наших же микробах весьма скудны, есть основания полагать, что отсутствие некоторых микробов и бактерий в организме может быть связано со здоровьем, метаболизмом и восприимчивости к аллергенам человека. Предварительные исследования на мышах показали, что метаболические заболевания вроде ожирения связаны с разнообразием и здоровой микрофлорой, а не нашей преобладающей точкой зрения «калории приходят, калории уходят».
Сейчас активно исследуются возможности внедрения определенных микробов и бактерий в организм человека, которые могут дать определенные преимущества, однако на момент написания статьи общие рекомендации по их использованию пока не были установлены.
Кроме того, бактерии сыграли важную роль в развитии научной мысли и человеческой медицины. Бактерии сыграли ведущую роль в развитии постулатов Коха 1884 года, которые привели к общему пониманию того, что болезни вызываются определенным видом микробов.
Исследователи, изучавшие бактерии, случайно открыли пенициллин — антибиотик, который спас множество жизней. Также совсем недавно в связи с этим был открыт легкий способ редактировать геном организмов, который может осуществить революцию в медицине.
По сути, мы только начинаем понимать, как извлекать пользу из нашего сожительства с этими маленькими друзьями. К тому же непонятно, кто истинный хозяин Земли: люди или микробы.
Бактерия

Бактерия – прокариотический (без типичного клеточного ядра и хромосомного аппарата), обычно одноклеточный микроорганизм. Бактерии Бактерии объединены в царство Eubacteria или Bacteria. Царство делят на несколько типов: Гр. могут образовывать ассоциации (группы) сходных клеток, характеризующиеся клеточными, но не организменными сходствами.
Бактерии Бактерии объединены в царство Eubacteria или Bacteria. Царство делят на несколько типов: Гр. объединены в царство Eubacteria или Bacteria Бактерии объединены в царство Eubacteria или Bacteria. Царство делят на несколько типов: Гр. . Царство делят на несколько типов: Грациликуты (Gracilicutes), Тенерикуты (Tenericutes), Мендосикуты (Mendosicutes).
Бактерии Бактерии объединены в царство Eubacteria или Bacteria. Царство делят на несколько типов: Гр. являются самой древней группой организмов из ныне существующих на Земле. Первые бактерии Бактерии объединены в царство Eubacteria или Bacteria. Царство делят на несколько типов: Гр. появились, вероятно, более 3,5 млрд лет назад и на протяжении почти миллиарда лет были единственными живыми существами на нашей планете. Поскольку это были первые представители живой природы, их тело имело примитивное строение.
Со временем их строение усложнилось, но и поныне бактерии Бактерии объединены в царство Eubacteria или Bacteria. Царство делят на несколько типов: Гр. считаются наиболее примитивными одноклеточными организмами. Интересно, что некоторые бактерии Бактерии объединены в царство Eubacteria или Bacteria. Царство делят на несколько типов: Гр. и сейчас ещё сохранили примитивные черты своих древних предков. Это наблюдается у бактерий Бактерии объединены в царство Eubacteria или Bacteria. Царство делят на несколько типов: Гр. , обитающих в горячих серных источниках и бескислородных илах на дне водоёмов.
Большинство бактерий Бактерии объединены в царство Eubacteria или Bacteria. Царство делят на несколько типов: Гр. бесцветно. Только немногие окрашены в пурпурный или в зелёный цвет. Но колонии многих бактерий Бактерии объединены в царство Eubacteria или Bacteria. Царство делят на несколько типов: Гр. имеют яркую окраску, которая обусловливается выделением окрашенного вещества в окружающую среду или пигментированием клеток.
Первооткрывателем мира бактерий Бактерии объединены в царство Eubacteria или Bacteria. Царство делят на несколько типов: Гр. был Антоний Левенгук — голландский естествоиспытатель 17 века, впервые создавший совершенную лупу-микроскоп, увеличивающую предметы в 160-270 раз.
Общая характеристика
Бактерии Бактерии объединены в царство Eubacteria или Bacteria. Царство делят на несколько типов: Гр. представляют собой одиночные клетки или простые ассоциации сходных клеток размером в среднем от 0,2 до 10 мкм. Нуклеоид (ядро) бактериальной клетки никогда не бывает отделен от цитоплазмы ядерной мембраной. Клеточные мембраны двухслойные липопротеидные, часто формируют разнообразные впячивания внутрь клетки. Липиды представлены триглицеринами.
Основной структурный компонент клеточной стенки многих бактерий Бактерии объединены в царство Eubacteria или Bacteria. Царство делят на несколько типов: Гр. – муреин. Бактерии Бактерии объединены в царство Eubacteria или Bacteria. Царство делят на несколько типов: Гр. чувствительны к антибиотикам. Питание гетеро- или автотрофное. Представители ряда групп способны к фото- и хемосинтезу. В качестве фотосинтетического пигмента присутствует пигмент бактериохлорофилл или (у цианобактерий) хлорофилл.
Распостранение
В силу простоты организации и неприхотливости бактерии Бактерии объединены в царство Eubacteria или Bacteria. Царство делят на несколько типов: Гр. широко распространены в природе. Бактерии Бактерии объединены в царство Eubacteria или Bacteria. Царство делят на несколько типов: Гр. обнаружены везде: в капле даже самой чистой родниковой воды, в крупинках почвы, в воздухе, на скалах, в полярных снегах, песках пустынь, на дне океана, в добытой с огромной глубины нефти и даже в воде горячих источников с температурой около 80ºС. Обитают они на растениях, плодах, у различных животных и у человека в кишечнике, ротовой полости, на конечностях, на поверхности тела.
Бактерии — самые мелкие и самые многочисленные живые существа. Благодаря малым размерам они легко проникают в любые трещины, щели, поры. Очень выносливы и приспособлены к различным условиям существования. Переносят высушивание, сильные холода, нагревание до 90ºС, не теряя при этом жизнеспособность.
Практически нет места на Земле, где не встречались бы бактерии Бактерии объединены в царство Eubacteria или Bacteria. Царство делят на несколько типов: Гр. , но в разных количествах. Условия жизни бактерий Бактерии объединены в царство Eubacteria или Bacteria. Царство делят на несколько типов: Гр. разнообразны. Одним из них необходим кислород воздуха, другие в нём не нуждаются и способны жить в бескислородной среде.
В воздухе: бактерии Бактерии объединены в царство Eubacteria или Bacteria. Царство делят на несколько типов: Гр. поднимаются в верхние слои атмосферы до 30 км. и больше.
Особенно много их в почве. В 1 г. почвы могут содержаться сотни миллионов бактерий Бактерии объединены в царство Eubacteria или Bacteria. Царство делят на несколько типов: Гр. .
В воде: в поверхностных слоях воды открытых водоёмов. Полезные водные бактерии Бактерии объединены в царство Eubacteria или Bacteria. Царство делят на несколько типов: Гр. минерализуют органические остатки.
В живых организмах: болезнетворные бактерии Бактерии объединены в царство Eubacteria или Bacteria. Царство делят на несколько типов: Гр. попадают в организм из внешней среды, но лишь в благоприятных условиях вызываю заболевания. Симбиотические живут в органах пищеварения, помогая расщеплять и усваивать пищу, синтезируют витамины.
Форма тела
Бактерии — многочисленные и разнообразные организмы. Они различаются по форме.
Способы передвижения
Строение жгутиков бактерий
Среди бактерий Бактерии объединены в царство Eubacteria или Bacteria. Царство делят на несколько типов: Гр. есть подвижные и неподвижные формы. Подвижные передвигаются за счёт волнообразных сокращений или при помощи жгутиков Жгутики – нитевидные структуры, расположенные на поверхности клетки и являющиес. (скрученные винтообразные нити), которые состоят из особого белка флагеллина. Жгутиков Жгутики – нитевидные структуры, расположенные на поверхности клетки и являющиес. может быть один или несколько. Располагаются они у одних бактерий Бактерии объединены в царство Eubacteria или Bacteria. Царство делят на несколько типов: Гр. на одном конце клетки, у других — на двух или по всей поверхности.
Но движение присуще и многим иным бактериям Бактерии объединены в царство Eubacteria или Bacteria. Царство делят на несколько типов: Гр. , у которых жгутики Жгутики – нитевидные структуры, расположенные на поверхности клетки и являющиес. отсутствуют. Так, бактерии Бактерии объединены в царство Eubacteria или Bacteria. Царство делят на несколько типов: Гр. , покрытые снаружи слизью, способны к скользящему движению.
У некоторых лишённых жгутиков Жгутики – нитевидные структуры, расположенные на поверхности клетки и являющиес. водных и почвенных бактерий Бактерии объединены в царство Eubacteria или Bacteria. Царство делят на несколько типов: Гр. в цитоплазме имеются газовые вакуоли. В клетке может быть 40-60 вакуолей. Каждая из них заполнена газом (предположительно — азотом). Регулируя количество газа в вакуолях, водные бактерии Бактерии объединены в царство Eubacteria или Bacteria. Царство делят на несколько типов: Гр. могут погружаться в толщу воды или подниматься на её поверхность, а почвенные бактерии — передвигаться в капиллярах почвы.
Внешнее строение
Клетка бактерии Бактерии объединены в царство Eubacteria или Bacteria. Царство делят на несколько типов: Гр. одета особой плотной оболочкой — клеточной стенкой, которая выполняет защитную и опорную функции, а также придаёт бактерии Бактерии объединены в царство Eubacteria или Bacteria. Царство делят на несколько типов: Гр. постоянную, характерную для неё форму. Клеточная стенка бактерии Бактерии объединены в царство Eubacteria или Bacteria. Царство делят на несколько типов: Гр. напоминает оболочку растительной клетки. Она проницаема: через неё питательные вещества свободно проходят в клетку, а продукты обмена веществ выходят в окружающую среду. Часто поверх клеточной стенки у бактерий Бактерии объединены в царство Eubacteria или Bacteria. Царство делят на несколько типов: Гр. вырабатывается дополнительный защитный слой слизи — капсула. Толщина капсулы может во много раз превышать диаметр самой клетки, но может быть и очень небольшой. Капсула — не обязательная часть клетки, она образуется в зависимости от условий, в которые попадают бактерии Бактерии объединены в царство Eubacteria или Bacteria. Царство делят на несколько типов: Гр. . Она предохраняет бактерию Бактерии объединены в царство Eubacteria или Bacteria. Царство делят на несколько типов: Гр. от высыхания.
На поверхности некоторых бактерий Бактерии объединены в царство Eubacteria или Bacteria. Царство делят на несколько типов: Гр. имеются длинные жгутики Жгутики – нитевидные структуры, расположенные на поверхности клетки и являющиес. (один, два или много) или короткие тонкие ворсинки. Длина жгутиков Жгутики – нитевидные структуры, расположенные на поверхности клетки и являющиес. может во много раз превышать разметы тела бактерии Бактерии объединены в царство Eubacteria или Bacteria. Царство делят на несколько типов: Гр. . С помощью жгутиков Жгутики – нитевидные структуры, расположенные на поверхности клетки и являющиес. и ворсинок бактерии Бактерии объединены в царство Eubacteria или Bacteria. Царство делят на несколько типов: Гр. передвигаются.

Строение бактериальной клетки
Внутреннее строение бактерий
Внутри клетки бактерии Бактерии объединены в царство Eubacteria или Bacteria. Царство делят на несколько типов: Гр. находится густая неподвижная цитоплазма. Она имеет слоистое строение, вакуолей нет, поэтому различные белки (ферменты) и запасные питательные вещества размещаются в самом веществе цитоплазмы. Клетки бактерий Бактерии объединены в царство Eubacteria или Bacteria. Царство делят на несколько типов: Гр. не имеют ядра. В центральной части их клетки сконцентрировано вещество, несущее наследственную информации. Бактерии Бактерии объединены в царство Eubacteria или Bacteria. Царство делят на несколько типов: Гр. , — нуклеиновая кислота — ДНК. Но это вещество не оформлено в ядро.
Внутренняя организация бактериальной клетки сложна и имеет свои специфические особенности. Цитоплазма отделяется от клеточной стенки цитоплазматической мембраной. В цитоплазме различают основное вещество, или матрикс, рибосомы и небольшое количество мембранных структур, выполняющих самые различные функции (аналоги митохондрий, эндоплазматической сети, аппарата Гольджи). В цитоплазме клеток бактерий Бактерии объединены в царство Eubacteria или Bacteria. Царство делят на несколько типов: Гр. часто содержатся гранулы различной формы и размеров. Гранулы могут состоять из соединений, которые служат источником энергии и углерода. В бактериальной клетке встречаются и капельки жира.
В центральной части клетки локализовано ядерное вещество — ДНК, не отграниченная от цитоплазмы мембраной. Это аналог ядра — нуклеоид. Нуклеоид не обладает мембраной, ядрышком и набором хромосом.
Роль бактерий в природе
Круговорот
Бактерии — важнейшее звено общего круговорота веществ в природе. Растения создают сложные органические вещества из углекислого газа, воды и минеральных солей почвы. Эти вещества возвращаются в почву с отмершими грибами, растениями и трупами животных. Бактерии Бактерии объединены в царство Eubacteria или Bacteria. Царство делят на несколько типов: Гр. разлагают сложные вещества на простые, которые снова используют растения.
Бактерии Бактерии объединены в царство Eubacteria или Bacteria. Царство делят на несколько типов: Гр. разрушают сложные органические вещества отмерших растений и трупов животных, выделения живых организмов и разные отбросы. Питаясь этими органическими веществами, сапрофитные бактерии Бактерии объединены в царство Eubacteria или Bacteria. Царство делят на несколько типов: Гр. гниения превращают их в перегной. Это своеобразные санитары нашей планеты. Таким образом, бактерии Бактерии объединены в царство Eubacteria или Bacteria. Царство делят на несколько типов: Гр. активно участвуют в круговороте веществ в природе.
Почвообразование
Поскольку бактерии Бактерии объединены в царство Eubacteria или Bacteria. Царство делят на несколько типов: Гр. распространены практически повсеместно и встречаются в огромном количестве, они во многом определяют различные процессы, происходящие в природе. Осенью опадают листья деревьев и кустарников, отмирают надземные побеги трав, опадают старые ветки, время от времени падают стволы старых деревьев. Всё это постепенно превращается в перегной. В 1 см 3 . поверхностного слоя лесной почвы содержатся сотни миллионов сапрофитных почвенных бактерий Бактерии объединены в царство Eubacteria или Bacteria. Царство делят на несколько типов: Гр. нескольких видов. Эти бактерии Бактерии объединены в царство Eubacteria или Bacteria. Царство делят на несколько типов: Гр. превращают перегной в различные минеральные вещества, которые могут быть поглощены из почвы корнями растений.
Некоторые почвенные бактерии Бактерии объединены в царство Eubacteria или Bacteria. Царство делят на несколько типов: Гр. способны поглощать азот из воздуха, используя его в процессах жизнедеятельности. Эти азотофиксирующие бактерии Бактерии объединены в царство Eubacteria или Bacteria. Царство делят на несколько типов: Гр. живут самостоятельно или поселяются в корнях бобовых растений. Проникнув в корни бобовых, эти бактерии Бактерии объединены в царство Eubacteria или Bacteria. Царство делят на несколько типов: Гр. вызывают разрастание клеток корней и образование на них клубеньков.
Эти бактерии Бактерии объединены в царство Eubacteria или Bacteria. Царство делят на несколько типов: Гр. выделяют азотные соединения, которые используют растения. От растений бактерии Бактерии объединены в царство Eubacteria или Bacteria. Царство делят на несколько типов: Гр. получают углеводы и минеральные соли. Таким образом, между бобовым растением и клубеньковыми бактериями Бактерии объединены в царство Eubacteria или Bacteria. Царство делят на несколько типов: Гр. существует тесная связь, полезная как одному, так и другому организму. Это явление носит название симбиоза.
Благодаря симбиозу с клубеньковыми бактериями Бактерии объединены в царство Eubacteria или Bacteria. Царство делят на несколько типов: Гр. бобовые растения обогащают почву азотом, способствуя повышению урожая.
Читайте также:
- Пищевое отравление микроспоридиями и его лечение
- Показания для пересадки печени при отравлении парацетамолом
- Задержка внутриутробного развития плода. Частота задержки внутриутробного развития плода
- Схема митоза и его фазы
- Замедление кровотока как причина сладжирования. Нарушения коагуляции - тромбогеморрагический синдром
